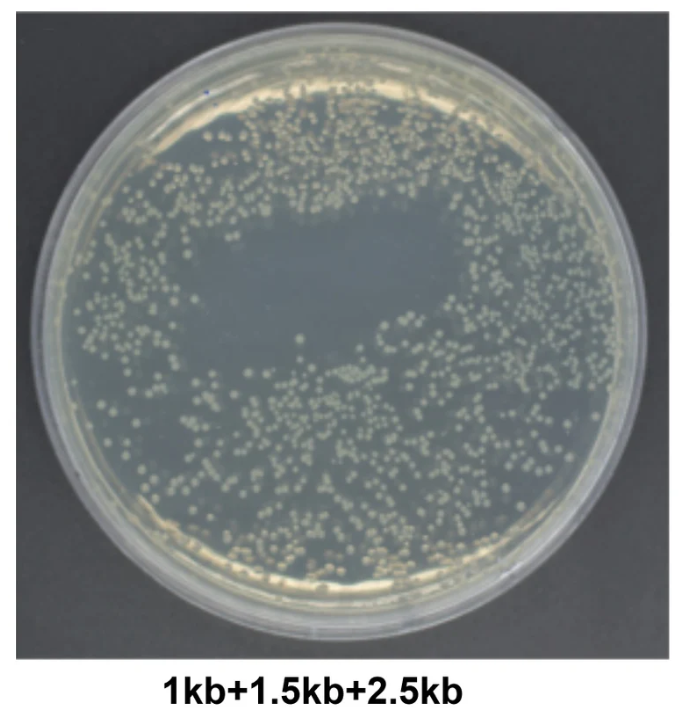
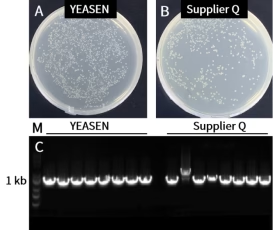

YEASEN은 생명과학 연구 및 진단을 위한 고품질의 연구용 시약과 기기를 제공하는 글로벌 바이오 기업입니다.

제품 설명
Hieff Clone™ Universal II One Step Cloning Kit
제품 번호
10923ES
제품 설명
Description
Hieff Clone™ Universal II One Step Cloning Kit is a newly upgraded cloning kit.
The carefully optimized 2nd generation 2× Hieff Clone™ Universal II Enzyme Premix combines the recombinant enzyme and the buffer required for the recombinant reaction with the addition of a unique recombinant enhancer to significantly improve the efficiency of recombinant cloning.
The kit can be directed to clone PCR products to any site of any vector, compatible with unpurified PCR products, directly recovered PCR products, low concentration of rubber recovered products, this product can reassemble the homologous arm GC content of 30%-70% of the joint fragment. The vector was completely linearized, and homologous sequences of the end of the linearized vector of 15-25 bp were introduced into the 5 'end of the positive and reverse PCR primers of the inserted fragment, so that the 5' and 3 'ends of the PCR products of the inserted fragment had exactly the same sequence corresponding to the two ends of the linearized vector, respectively. Under the action of recombinant enzyme, the recombinant reaction of PCR product and linearized vector can be completed in as little as 5 min at 50℃. The positive rate of cloning can reach more than 95%.
Features
Simple: Clone up to six DNA fragments in a single reaction.
Flexible: Design guidelines allow assembly into any vector of your choice.
Efficient: Efficient for ligation of one to seven fragments.
Applications
Rapid Cloning: It allows multiple overlapping DNA fragments to be seamlessly linked in a one-step, 5–50 minute isothermal reaction.
Directed Cloning; Site-Directed Mutagenesis.
Specifications
Ligation | Up to 7 fragments |
Product type | DNA Assembly |
Storage
This product should be stored at -25~-15℃ for 1 years.
Components
Components No. | Name | 10923ES05 (5 T) | 10923ES20 (20 T) | 10923ES50 (50 T) |
10923-A | 2 × Hieff CloneTM Universal II Enzyme Premix | 50 μL | 200 μL | 500 μL |
10923-B | 500 bp control insert (25 ng/μL) | 5 μL | 5 μL | 5 μL |
10923-C | pUC 19 control vector, linearized (50 ng/μL) | 5 μL | 5 μL | 5 μL |
Figures
Figure 1. 10 ng low-input single fragments were connected in the non-resuscitation receptive state of the 6μL small system. The results showed that 10923ES had better performance than competing products, with high connection efficiency, more colonies and a positive rate of 100%. A-B: Clony plate. The molar ratio of carrier (10 kb) to insert fragment (1 kb) was 1:2. C: Electrophoresis map identified by insertion fragment PCR, M: YEASEN 10505ES.
Figure 2. Six fragments (a total length of 7.6 kb) was cloned into a 11.6 kb plasmid. The results showed that 10923ES had better performance than competing products, with more colonies and positive rate of 100%. A-B: Colony plate. The molar ratio of carrier (11.6 kb) to insert fragments was 1:2. C: Electrophoresis analysis of the insertion fragment, M: YEASEN 10505ES. Plasmid input:200 ng/20 μL, 50°C, 50 mins.
Figure 3. Ligation of ultra long fragments. The results show that the number of colonies in 10923ES is high, with a positive rate of 100%.A: Recombinant transformation plate. The molar ratio of the vector (21 kb) to the insert fragment (4.5 kb) is 1:2.B: PCR identification electrophoresis of the insert fragment, M: Yeasen 10505ES. Vector amount: 200 ng in a 20 μL reaction system, reaction conditions: 50°C, 40 min.
Related Citations & References
[1] Zhang H, Shao S, Zeng Y, et al. Reversible phase separation of HSF1 is required for an acute transcriptional response during heat shock. Nat Cell Biol. 2022;24(3):340-352. (IF:28.824)
[2] Xu Y, Yu Q, Wang P, et al. A Selective Small-Molecule c-Myc Degrader Potently Regresses Lethal c-Myc Overexpressing Tumors. Adv Sci (Weinh). 2022;9(8):e2104344. (IF:16.806)
[3] Guan B, Jiang YT, Lin DL, Lin WH, Xue HW. Phosphatidic acid suppresses autophagy through competitive inhibition by binding GAPC (glyceraldehyde-3-phosphate dehydrogenase) and PGK (phosphoglycerate kinase) proteins [published online ahead of print, 2022 Mar 15]. Autophagy. 2022;1-15. (IF:16.016)
[4] He X, Li Y, Chen Q, et al. O-GlcNAcylation and stablization of SIRT7 promote pancreatic cancer progression by blocking the SIRT7-REGγ interaction [published online ahead of print, 2022 Apr 14]. Cell Death Differ. 2022;10.1038/s41418-022-00984-3.(IF:15.828)
[5] Zhou T, Zhu X, Ye Z, et al. Lupus enhancer risk variant causes dysregulation of IRF8 through cooperative lncRNA and DNA methylation machinery. Nat Commun. 2022;13(1):1855. Published 2022 Apr 6. (IF:14.919)
[6] Li T, Chen X, Qian Y, et al. A synthetic BRET-based optogenetic device for pulsatile transgene expression enabling glucose homeostasis in mice. Nat Commun. 2021;12(1):615. Published 2021 Jan 27. (IF:14.919)
[7] Wu P, Zhang T, Liu B, et al. Mechano-regulation of Peptide-MHC Class I Conformations Determines TCR Antigen Recognition. Mol Cell. 2019;73(5):1015-1027.e7. (IF:14.548)
[8] Xiong L, Liu S, Chen S, et al. A new type of DNA phosphorothioation-based antiviral system in archaea. Nat Commun. 2019;10(1):1688. Published 2019 Apr 11. (IF:11.878)
[9] Jiang L, Wang Y, Xia A, et al. A natural single-nucleotide polymorphism variant in sulfite reductase influences sulfur assimilation in maize. New Phytol. 2021;232(2):692-704. (IF:10.152)
YEASEN의 모든 제품을 만나 보세요!
Biopharma
mRNA enzyme
Nucleotides
Viral Vector Manufacturing
Quality Analysis Kit
NGS Library Preparation
Adapter
DNA Library Preparation
RNA Library Preparation
NGS Module
NGS enzyme
Magnetic Bead
Library Quantitation
Molecular Diagnostics
Glycerol-free Enzyme
RT-qPCR Enzyme
RT-LAMP Enzyme
dNTPs
IVD Kit
Life Science Reagents
Hot Products
Molecular Biology
Cell Culture & Analysis
Protein Research
Animal Model
Others
YEASEN - Official Distributor in South Korea "Morebio" 한국 공식 대리점 "모아바이오"